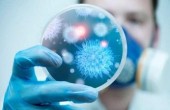

يبدو أن المرض الذي يسببه فيروس كورونا المستجد لا يزال يحتفظ ببعض أسرار، حيث تتكشف على فترات معلومات جديدة عن وباء "كوفيد 19"، لا سيما فيما يتعلق بأعراضه.
فقد كشف مجموعة من المصابين بالفيروس، عن أعراض جديدة ظهرت عليهم، بالإضافة إلى الأعراض المتعارف عليها مثل السعال والحمى.
وأشار مصابون بـ"كوفيد 19" إلى عارض مشترك لم يتطرق له الأطباء، تمثل في خدر (تنميل) في الجسم.
وتحدثت غريس دودلي التي هزمت كورونا لصحيفة "ميرور" البريطانية، بعد أن أمضت 10 أيام في قسم العناية المركزة داخل مستشفى "كوينز" في رومفور شرقي لندن، فيما لا يزال والدها يحارب الفيروس.
وقالت: "بعد 6 أيام (من الإصابة) شعرت بأنني لست على ما يرام واحتجت لأن أستلقي، مع شعوري بالخدر في جلدي. بعد 24 ساعة لم أشعر بمثل هذا التعب في حياتي، لقد كنت أتجمد من البرد ولم أكن قادرة على البقاء مستيقظة لفترات طويلة".
وذكر مستخدم لـ"تويتر" قال إنه أصيب بكورونا، أن أكثر الأعراض التي ضايقته كان "الشعور بالخدر في مختلف أنحاء الجسم"، فيما أوضحت تارانا بورك أنها أحست بنفس الشعور في صدرها.
وقالت: "إنه بالتأكيد كورونا. هذا الشعور وصل إلى صدري هذا المساء، وكأن هناك خدرا داخل قفصي الصدري عندما أشهق. قادرة على التنفس لكن الأمر مزعج".
كما أوضحت أن صديقها أصيب بتهيج في الجلد، مما اضطره لللاستعانة بدهان يستخدم في معالجة حروق الشمس، للمساعدة في التخفيف من آلامه، بحسب "ميرور".
يذكر أن أعراض الإصابة بكورونا قد لا تقتصر على السعال وضيق التنفس والشكوى من الجهاز التنفسي، بل إن التغيرات الهضمية المفاجئة كالقيء والإسهال، أو حتى فقدان حاستي الشم والتذوق، قد تكون إنذارا بالإصابة بالفيروس.